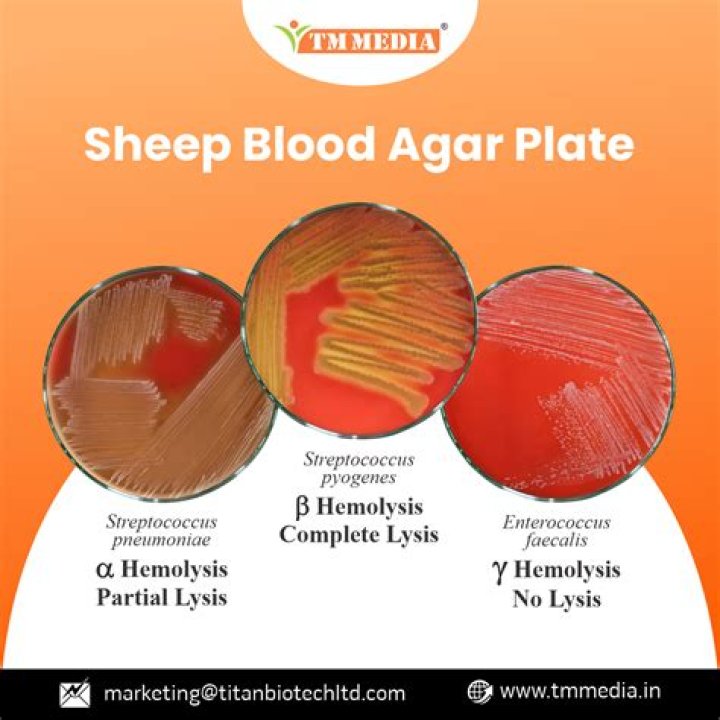

Why sheep blood is used in blood agar?
Sheep blood has been preffered source in the Blood agar due to the fact that sheep RBCs are most sensitive to the the hemolytic toxins released by bacterial cells thus causing hemolytic zones around the colonies over the period of time.
Why is sheep blood agar used?
Blood agar contains general nutrients and 5% sheep blood. It is useful for cultivating fastidious organisms and for determining the hemolytic capabilities of an organism. Some bacteria produce exoenzymes that lyse red blood cells and degrade hemoglobin; these are called hemolysins.
Why is human blood not used in blood agar?
Agar prepared with human blood is not recommended, partly because of the safety risk to laboratory personnel, but mainly because it is said to result in poor bacterial isolation rates, although there are few published data to support this (2).
What is the purpose of adding sheep's blood to an agar culture medium?
About 5% of defibrinated mammalian blood (human, sheep, or horse) is added to the autoclaved basal media to prepare blood agar medium. It is an enriched medium that supports the growth of fastidious bacteria and inhibits the growth of some bacteria like Neisseria and Haemophilus.
Why is horse blood used in blood agar?
Horse blood allows detection of hemolytic reactions and supplies both the X factor (heme) and the V factor (nicotinamide adenine dinucleotide, NAD), necessary for the growth of many bacterial species, including Haemophilus influenzae, which requires both the X and V factors.
Microbiology: Hemolysis/Blood Agar
31 related questions foundIs sheep blood agar selective?
BD Group A Selective Strep Agar with 5% Sheep Blood (ssA™) is a selective medium for use in the isolation and presumptive identification of group A streptococci from throat cultures and other clinical specimens.
Why blood agar is selective media?
A selective media is composed of specific ingredients to inhibit the growth of certain species of microbes in a mixed culture while allowing others to grow. ... Blood agar is a differential medium that distinguishes bacterial species by their ability to break down red blood cells.
How do you get sheep blood for blood agar?
Blood collection and agar plate preparation
Hair sheep blood was obtained by venipuncture via the jugular vein (yielding 350 mL of blood per animal). An area approximately 100 cm2 on the front of the animal's chest was prepared by generously spraying with 70% ethanol.
Why is blood agar used for streptococcus?
Blood agar is commonly used to isolate not only streptococci, but also staphylococci and many other pathogens. Besides providing enrichments for the growth of fastidious pathogens, Blood agar can be used to detect hemolytic properties.
What is special about sheep's blood?
Sheep blood is one of the most widely used animal blood products in culture media. Fitzgerald Industries supplies high quality glutaraldehyde-stabilized albumin sensitized Sheep Red Blood Cells which are supplied lyophilized with added sodium azide as a preservative.
What is the difference between Alpha Beta and Gamma hemolysis?
The key difference between alpha beta and gamma hemolysis is that alpha hemolysis is the partial destruction of red blood cells in the blood and beta hemolysis is the complete destruction of red blood cells in the blood, while gamma hemolysis does not involve any breakdown of red blood cells.
Which blood is used in blood agar?
Blood agar is a general purpose, enriched medium often used to grow fastidious organisms and to differentiate bacteria based on their hemolytic properties. In the U.S., blood agar is usually prepared from tryptic soy agar or Columbia agar base with 5% sheep blood.
Why can most bacteria grow on blood agar?
Blood agar is a differential medium because all the bacteria will grow on it due to the nutrients and iron.
Does Streptococcus pyogenes grow on sheep blood agar?
GAS grows best on complex “rich” medium such as Trypticase Soy Agar (TSA) supplemented with 5% Sheep Blood, where it typically produces large zones of β-hemolysis (the complete disruption of erythrocytes and the release of hemoglobin) (Fig. 1). Therefore, S.
Is blood agar selective or differential media?
Blood agar is differential media because 3 different types of hemolysis, or lysing of red blood cells, can be seen on this plate. ... When combined with patient history and colony morphology, hemolysis observed on blood agar can help microbiologists make a presumptive organism identification.
What is the difference between serum and Defibrinated blood?
Serum is blood plasma from which fibrinogen or clotting factor is removed. It has neither blood cells nor clotting factors. On the other hand, defibrinated blood is blood from which clotting factor or fibrinogen is removed. It still has othet components of blood like blood cells.
What media is used for blood culture?
The quality of brain-heart agar (BHA) was tested on 300 blood samples in 5% blood meat-pepton agar (MPA) and BHA in aerobic and anaerobic conditions for both the media. Aerobic microorganisms grew in BHA 2 times more often than in MPA. The microaerophilic microbes grew in BHA 3,6 times more often than in MPA.
What Bacteria grows on sheep blood agar?
Blood Agar is used to grow a wide range of pathogens particularly those that are more difficult to grow such as Haemophilus influenzae, Streptococcus pneumoniae and Neisseria species. It is also required to detect and differentiate haemolytic bacteria, especially Streptococcus species.
Why MacConkey agar is selective?
MacConkey Agar Is Selective for Non-fastidious Gram-negative Organisms. Therefore, MacConkey needed a way to limit this background of environmental flora and allow only his organisms of interest to grow. A medium that can perform this function is now known as a selective medium.
What is difference between selective and differential media?
Selective media generally selects for the growth of a desired organism, stopping the growth of or altogether killing non-desired organisms. Differential media takes advantage of biochemical properties of target organisms, often leading to a visible change when growth of target organisms are present.
Does blood agar grow Gram-negative?
Contains blood cells from an animal (e.g. a sheep); most bacteria will grow on this medium. ... This is an agar upon which only Gram-negative bacteria can grow.
What is the bacitracin test used for?
Purpose and Scope: The bacitracin susceptibility test is used to distinguish Group A streptococci, from other streptococci. When grown on blood agar, Group A streptococci are sensitive to (killed by) the antibiotic bacitracin.
What is Gamma hemolysis?
Gamma hemolysis is a lack of hemolysis in the area around a bacterial colony. A blood agar plate displaying gamma hemolysis actually appears brownish. This is a normal reaction of the blood to the growth conditions used (37° C in the presence of carbon dioxide).
What does a blood agar test for?
BAP tests the ability of an organism to produce hemolysins, enzymes that damage/lyse red blood cells (erythrocytes). The degree of hemolysis by these hemolysins is helpful in differentiating members of the genera Staphylococcus, Streptococcus and Enterococcus.
What is purpose of blood in sheep blood agar plate quizlet?
Blood agar plate- tripticase soy agar plate containing 5% sheep red blood cells which supports the growth of most medically important bacteria and it is used to detect the hemolysis patterns of streptococci isolated from clinical specimens.



